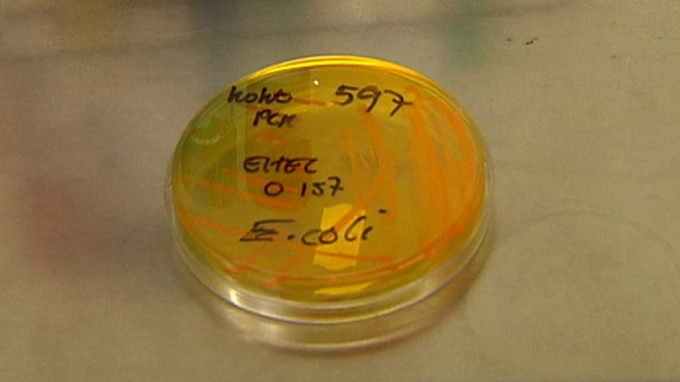
Uwaga ! Bakterie E-coli atakują

Foto: iLogic Media |
Bakterie E. coli, które zostały odkryte w związku z ogniskiem zakażenia, to rodzaj O157, pierwszy raz , ten rodzaj bakterii stwierdzono w Norwegii.Szczep który jest bardzo rzadki ,występował wcześniej w Niemczech. Jednak nigdy nie udało sie odkryć źródła zakażeń. Urząd ds. Bezpieczeństwa Żywności pracuje intensywnie, aby znaleźć przyczynę zakażenia. Próbki zostały wysłane do Narodowego Instytutu Weterynaryjnego w celu analizy. Do tej pory źródło zakażeniem pozostaje nieznane. Znalezienie przyczyn jest trudne i czasochłonne.Wynik ibadania zostana ogloszone w najblizszym czasie.
Instytut Zdrowia Publicznego prosi o zwiększenie higieny podczas przygotowywania posiłków.
Bakterie E-coli -(Gronkowce )występują w jamie nosowo-gardłowej oraz na skórze ludzi i zwierząt.Wytwarzają termoodporną enterotoksynę. Toksyna jest bardzo odporna na działanie wysokiej temperatury.
Szacuje się, że 10 do 50% populacji ludzkiej stale lub okresowo jest nosicielami tych bakterii bez wystąpienia objawów chorobowych. Objawy zatrucia pokarmowego gronkowcem występują szybko po zakażeniu (1,6 godzin). Początkowo pojawiają się intensywne wymioty, bóle nadbrzusza, biegunka, osłabienie krążenia. Temperatura jest tylko nieznacznie podwyższona, może być też obniżona. Zatrucie szczepami gronkowca może spowodować zapaść i zagrożenie zgonem.
Przy zakażeniu wskutek bezpośredniego kontaktu (np. gdy bakteria jest w wodzie) S. aureus najczęściej powoduje zakażenia ropne skóry, tkanek podskórnych oraz tkanek miękkich, zakażenia układowe, zakażenia lub zatrucia związane z produkcją toksyn.
Gronkowce mogą być odporne na antybiotyki, dlatego coraz częściej poza antybiotykami w leczeniu zaburzeń relacji "gronkowce-człowiek" stosuje się metody alternatywne, probiotyki, barwniki roślinne, immunostymulacje itp. Niestety nie istnieje jeszcze bezpieczna specyficzna szczepionka przeciwgronkowcowa.
Escherichia coli inaczej Pałeczka okrężnicy potocznie nazywana bakterią koli - pod tą nazwą kryje się prawie 200 różnych bakterii należących do tego samego gatunku. Wchodzą one w skład fizjologicznej flory bakteryjnej jelita grubego człowieka oraz zwierząt stałocieplnych. Obecność E. coli w wodach powierzchniowych jest często stosowanym wskaźnikiem ich zanieczyszczenia.
Bakterie E. coli, które są nieszkodliwe w jelicie, mogą powodować schorzenia innych układów. Są najczęstszą przyczyną zakażeń (60-80%) dróg moczowych. Są też drugim czynnikiem etiologicznym zapalenia opon mózgowych u noworodków. Niektóre szczepy E.coli produkujące egzotoksynę. Czasem powodują zatrucia pokarmowe, najczęściej spowodowane spożyciem zakażonego pokarmu.
Przebieg schorzenia ma różne nasilenie, czasem może być bardzo groźne, ale w większości objawy nie jest ciężkie. Sporadycznie zdarzają się ostre schorzenia żołądka i jelit, występujące w krótkim czasie po spożyciu pokarmów lub wody zakażonych drobnoustrojami lub ich jadami.
Do głównych objawów należą: biegunka, bóle brzucha, nudności, wymioty, bóle i zawroty głowy, niekiedy gorączka, ogólne osłabienie, objawy odwodnienia. Rozwój bakterii E. coli w przewodzie pokarmowym powoduje ciężkie schorzenia - zapalenia otrzewnej. E.coli jest najczęstszą pałeczką Gramm (-) powodującą sepsę.
Do walki z bakteriami E.coli oraz do wzmacniania organizmu i działania przeciwzapalnego stosuje się głównie antybiotyki.

Reklama
To może Cię zainteresować
8